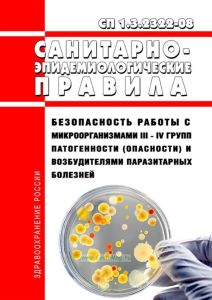
СП 1.3.2322-08 Безопасность работы с микроорганизмами III - IV групп патогенности (опасности) и возбудителями паразитарных болезней

- Артикул:00-01013458
- ISBN: 978-5-603080-23-9
- Обложка: Мягкая обложка
- Издательство: ЦЕНТРМАГ (все книги издательства)
- Город: Москва
- Страниц: 56
- Формат: А5 (148x210 мм)
- Год: 2026
- Вес: 67 г
Документ отменен в связи с изданием Постановления Главного государственного санитарного врача РФ от 28.01.2021 N 4 "Об утверждении санитарных правил и норм СанПиН 3.3686-21 "Санитарно-эпидемиологические требования по профилактике инфекционных болезней"
Постановление Главного государственного санитарного врача РФ от 28.01.2008 N 4 "Об утверждении санитарно-эпидемиологических правил СП 1.3.2322-08"
В соответствии с Федеральным законом от 30.03.1999 N 52-ФЗ "О санитарно-эпидемиологическом благополучии населения" и Постановлением Правительства Российской Федерации от 24.07.2000 N 554 "Об утверждении Положения о государственной санитарно-эпидемиологической службе Российской Федерации и Положения о государственном санитарно-эпидемиологическом нормировании" утверждены санитарно-эпидемиологические правила "Безопасность работы с микроорганизмами III - IV групп патогенности (опасности) и возбудителями паразитарных болезней. СП 1.3.2322-08" и введены в действие с 1 мая 2008 года.
Санитарные правила устанавливают требования к организационным, санитарно-противоэпидемическим (профилактическим) мероприятиям, направленным на обеспечение личной и общественной безопасности, защиту окружающей среды при работе с патогенными биологическими агентами III - IV групп - патогенными для человека микроорганизмами и гельминтами, а также любыми объектами и материалами, включая полевой, клинический, секционный, подозрительными на содержание указанных ПБА.
Содержание
Постановление
I. Область применения
II. Требования к организации работ с патогенными биологическими агентами III - IV групп
III. Требования к порядку действий по ликвидации аварий при работе с патогенными биологическими агентами
IV. Организация контроля выполнения требований биологической безопасности
Приложение N 1. Классификация микроорганизмов - возбудителей инфекционных заболеваний человека, простейших, гельминтов и ядов биологического происхождения по группам патогенности
Бактерии
I группа
II группа
III группа
IV группа
Риккетсии
II группа
III группа
Эрлихии (подсемейство Ehrlichiae, семейство Rickettsiaceae)
III группа
Вирусы
I группа
II группа
III группа
IV группа
Хламидии
II группа
III группа
Грибы
II группа
III группа
IV группа
Простейшие
III группа
IV группа
Гельминты
III группа
IV группа
Членистоногие
III группа
IV группа
Яды биологического происхождения
II группа
III группа
Приложение N 2. Режимы обеззараживания физическими методами различных объектов, контаминированных возбудителями III - IV групп патогенности
Приложение N 3. Режимы обеззараживания различных объектов внешней среды, контаминированных возбудителями паразитарных болезней (цистами и ооцистами простейших, яйцами и личинками гельминтов)
Приложение N 4. Порядок замены фильтров тонкой очистки воздуха вытяжной системы вентиляции и определение их защитной эффективности
Приложение N 5. Схема контроля фильтра при работающей вентиляционной системе
Библиографические данные